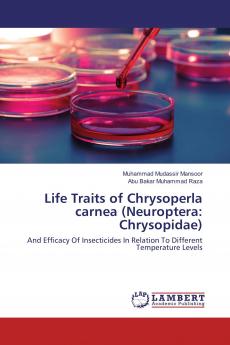
Life Traits of Chrysoperla carnea (Neuroptera: Chrysopidae)

English
Paperback
₹5772
(All inclusive*)
Delivery Options
Please enter pincode to check delivery time.
*COD & Shipping Charges may apply on certain items.
Review final details at checkout.
Looking to place a bulk order? SUBMIT DETAILS
About The Book
Description
Author
The common green lacewing Chrysoperla carnea is a key biological control agent employed in integrated pest management (IPM) programs for managing various insect pests. The use of insecticide-resistant natural enemies can prevent secondary pest outbreaks and pest resurgence in many cropping systems in which chemical management of pests is a common practice. In the field temperature has a prominent effect on insecticide effectiveness. It is a key factor of the environment which acts as a controlling and lethal factor. Temperature coefficient of any insecticide may be calculated to find the temperature-toxicity association. Insecticides with a positive temperature coefficient become more toxic with the increase in temperature whereas those with a negative temperature coefficient become more toxic at lower temperatures.
Delivery Options
Please enter pincode to check delivery time.
*COD & Shipping Charges may apply on certain items.
Review final details at checkout.
Details
ISBN 13
9783659855832
Publication Date
-31-03-2016
Pages
-88
Weight
-126 grams
Dimensions
-150x220x5.12 mm